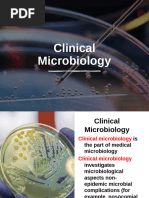

0% found this document useful (0 votes)
71 views6 pagesNormal Microbial Flora
The normal microbiota refers to the microorganisms that inhabit healthy humans, outnumbering human cells 10 to 1. These microbes collectively form the microbiome and provide defense against pathogens while assisting digestion and immune system development. The skin and mucous membranes harbor resident microbiota that reestablish and transient microbiota from the environment, which are generally harmless unless the resident flora is disturbed. Common bacteria found on human surfaces include Staphylococcus epidermidis, Streptococcus mitis, and various Lactobacillus species as beneficial flora and Staphylococcus aureus, Streptococcus pneumoniae, and Escherichia coli as potential pathogens if overgrowth occurs.
Uploaded by
Michelle De FreitasCopyright
© © All Rights Reserved
We take content rights seriously. If you suspect this is your content, claim it here.
Available Formats
Download as DOCX, PDF, TXT or read online on Scribd
0% found this document useful (0 votes)
71 views6 pagesNormal Microbial Flora
The normal microbiota refers to the microorganisms that inhabit healthy humans, outnumbering human cells 10 to 1. These microbes collectively form the microbiome and provide defense against pathogens while assisting digestion and immune system development. The skin and mucous membranes harbor resident microbiota that reestablish and transient microbiota from the environment, which are generally harmless unless the resident flora is disturbed. Common bacteria found on human surfaces include Staphylococcus epidermidis, Streptococcus mitis, and various Lactobacillus species as beneficial flora and Staphylococcus aureus, Streptococcus pneumoniae, and Escherichia coli as potential pathogens if overgrowth occurs.
Uploaded by
Michelle De FreitasCopyright
© © All Rights Reserved
We take content rights seriously. If you suspect this is your content, claim it here.
Available Formats
Download as DOCX, PDF, TXT or read online on Scribd